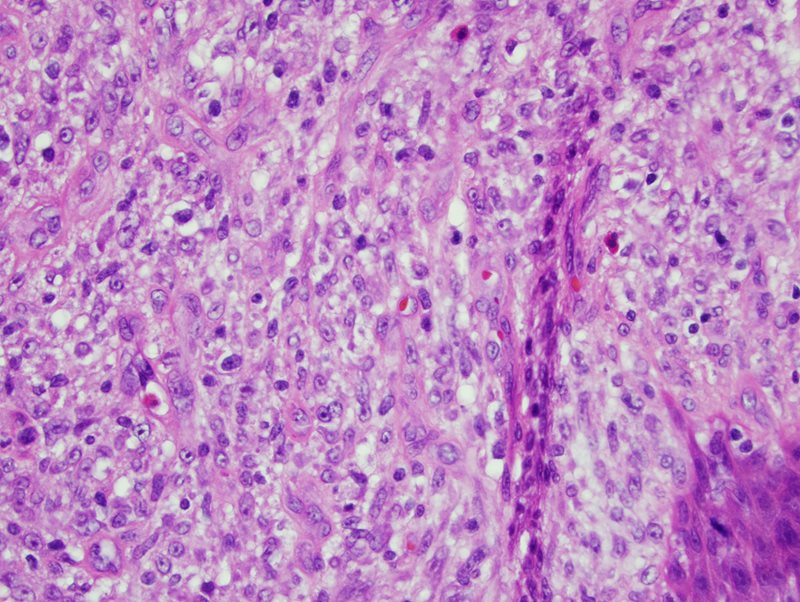

Case of the Month: Dysphonia
By Diana Agostini-Vulaj, D.O., PGY-4
Clinical History
A 39 year old female presented to the clinic complaining of loss of voice for the last 2 months.
Imaging
Past Medical History
There was no associated inciting illness or upper respiratory tract infection prior to the loss of voice reported by the patient. A positive history of tobacco use (about 2-5 cigarettes daily for 20 years) was elicited.
Recent History
A laryngoscopy was performed which revealed a large anterior commissure polypoid lesion in addition to edematous and erythematous vocal cords bilaterally. Plan was made for surgical resection.
Grossly, multiple aggregates of lobulated soft tissue were received. Histologically, the specimen consisted of unremarkable squamous mucosa with a prominent submucosal spindle cell mass with a fascicular to storiform growth pattern (Fig 1). The spindled cells showed ample eosinophilic cytoplasm, mild nuclear shape variation, inconspicuous nuclei, and few mitoses, none of which were atypical (Fig 2). Additionally, numerous inflammatory cells were identified including plasma cells, neutrophils, eosinophils, and lymphocytes (Fig 3).